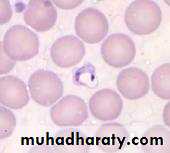

Blood & tissue protozoa of humans
TrypanosomaLeishmania
Malaria
Trypanosoma
Species pathogenic to man:T gambiense
T rhodesienseT cruzi
Morphology
Fusiform, Nucleus in the middle, posterior kinetoplast , anterior free flagellumMovement
ReproductionNourishment( blood, lymph , C.S.F)
Culture: NNN medium.
Life cycle
Ulternate existence in vertebrate &invertebrate host.T. gambiense( mid African sleeping sickness)
Vertebrate host : ManInvertebrate host : Tse Tse fly Glossina
Epidemiology
West & central AfricaTransmission : bite of tse tse fly ( after cyclic development of parasite).
Mechanical : During epidemics.
Pathology & symptomatology:
Acute stage : blood & lymphChronic stage : C.S.F.
Incubation period:
Acute stageChronic stageTrypanosoma rhodesiense( East African sleeping sickness)
Life cycle:Morphology:
Pathogenicity : More rapid ,severe, fatal than gambian Tryp.
Trypanosoma cruzi( American tryponosomiasis)
Morphology:Life cycle:
Vertebrate host (human , domesticated & wild animals)
Invertebrate host: Reduviid bugs .
Epidemiology
Pathology & symptoms:In the blood : Trypanosomal form
In the cells : Amastigote form.
Invade skeletal , cardiac & other muscle fibers